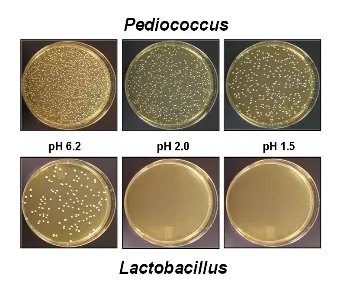

Maxxidigest 200g/375g 
MaxxipawsDesde 36,99 €
Apoyo digestivo e inmunológico avanzado para perros
Talla:
Elige una opción
El producto se ha añadido al carrito.
Agotado
Para nuestros perros, la función digestiva adecuada es fundamental para su bienestar general. Además de procesar la nutrición, el tracto digestivo también alberga muchos aspectos importantes de la función inmunológica. Cuando el tracto digestivo se desequilibra, ya sea por estrés, enfermedad, dieta inadecuada, medicamentos o cirugía, puede ser un largo camino de regreso para encontrar el equilibrio y el funcionamiento adecuado. Algunas de las afecciones digestivas más comunes que enfrentan los perros incluyen: flatulencia, diarrea, alergias alimentarias, intestino permeable (disbiosis), infecciones posquirúrgicas, terapias con antibióticos y trastornos gastrointestinales.
maxxidigest + utiliza el probiótico específico, Pediococcus acidilactici, como probiótico activo para ayudar a repoblar el sistema digestivo de la manera más eficiente posible. Se ha demostrado que P. acidilactici sobrevive en las duras condiciones ácidas que son exclusivas de los sistemas del perro, lo que les permite prosperar en los intestinos y comenzar a restablecer el equilibrio para la digestión y la inmunidad.
Combina prebióticos y probióticos con antioxidantes en un suplemento.
A diferencia de los suplementos digestivos tradicionales que solo contienen probióticos en forma de pastilla o masticables, nuestro polvo de enzimas contiene tanto probióticos como prebióticos.
Los prebióticos, en forma de lino, girasol y sésamo, proporcionan una nutrición valiosa para que los probióticos se afiancen y comiencen a florecer en el tracto digestivo.
Esto permite que los probióticos comiencen a eliminar la acumulación dañina, permitiendo que los ingredientes medicinales dentro de maxxidigest + y los medicamentos externos funcionen de manera eficiente.
maxxidigest + también está reforzado con una generosa porción de antioxidantes saludables y naturales, seleccionados a propósito para su capacidad para apoyar aún más la función digestiva y aliviar las respuestas hiperactivas o inflamatorias en todo el cuerpo.
En el momento de la fabricación, agregan un 50% de excedente que garantiza mil millones de Unidades Formadoras de Colonias por porción en la fecha de vencimiento, no solo en la fecha de fabricación.
Diseñado para administrarse fácilmente con las comidas.
Simplemente rocía la dosis diaria en dos comidas al día, permitiendo la máxima absorción de todos los ingredientes. Nuestra formulación en polvo te permite dar la cantidad exacta necesaria, lo que facilita aumentar o disminuir según la recomendación de tu veterinario.
Recomendamos duplicar la dosis diaria durante las primeras semanas de uso del suplemento mientras se regula la condición.
Diseñado específicamente para el tracto digestivo único de los perros.
Los perros tienen un nivel de ácido más alto en el estómago, con niveles de pH entre 1 y 2.
Muchos de los probióticos que son valiosos para los humanos, no pueden sobrevivir en el ambiente hostil dentro del estómago de los perros y continúan hasta sus tractos gastrointestinales. Es por eso que elegimos específicamente P. acidilactici, sobre Bifidobacteria y Lactobacillus, como nuestro principal probiótico.
P. acidilactici es una bacteria beneficiosa que existe naturalmente en el tracto gastrointestinal (GI) humano y animal. Pertenece a General Regarded As Safe (GRAS) desde la perspectiva del Departamento de Alimentos y Medicamentos de EE. UU. (FDA).
La investigación en animales ha confirmado que P. acidilactici no solo es útil para aliviar los efectos secundarios de los medicamentos cuando se administra junto con el tratamiento con medicamentos. También ayuda a los perros a acelerar su recuperación de enfermedades agudas o crónicas. Apoya una respuesta inflamatoria e inmunológica saludable en los intestinos y se ha demostrado que disminuye la presencia de bacterias patógenas (dañinas).
Además, hemos seleccionado específicamente L-Glutamina como nuestro aminoácido para ayudar a fortalecer el revestimiento intestinal, aliviando el intestino permeable y la inflamación.
Metilsulfonilmetano (MSM) por su apoyo a la función autoinmune adecuada, y N-Acetil-D-Glucosamina (NAG) por su apoyo comprobado para la osteoartritis y las enfermedades inflamatorias del intestino, incluida la colitis ulcerosa y la enfermedad de Crohn.
Todos los ingredientes adicionales de maxxidigest + apoyan la función inmunológica y gastrointestinal saludable del perro.
Soporte comprobado para perros con digestión sensible, con medicamentos o en recuperación de una cirugía.
Cuando te enfrentas a problemas de salud que afectan el estómago sensible de tu perro, puede ser difícil elegir un camino. Especialmente si los problemas estomacales son causados por medicamentos destinados a ayudar con otros problemas de salud.
Con maxxidigest + comprendemos la naturaleza interrelacionada del tracto digestivo de tu perro y nos tomamos en serio su función. maxxidigest + combina ingredientes probados para restaurar la salud digestiva al estabilizar el nivel de pH en el intestino y repoblar el tracto gastrointestinal con probióticos saludables para mejorar el revestimiento de la mucosa.
Pero incluso más que eso, ofrece alivio de la diarrea, ayuda con las sensibilidades alimentarias y las alergias.
Seguro para uso diario y a largo plazo.
Incluso los perros con tractos digestivos saludables pueden beneficiarse de maxxidigest +, es seguro para el uso diario y a largo plazo.
Y en nuestra base en polvo diseñada para administrarse fácilmente con las comidas, es una manera fácil de proporcionar aminoácidos esenciales y un refuerzo antioxidante valioso incluso para perros sanos de todas las razas y tamaños.
Resumen:
- Puede ayudar con el intestino permeable, la reparación intestinal, el síndrome del intestino irritable (SII), la enfermedad inflamatoria del intestino (EII), la infección por levaduras, la dermatitis atópica, la alergia alimentaria, la flatulencia, las infecciones posquirúrgicas, la diarrea crónica (incluido el malestar estomacal asociado a los antibióticos), mejora la función hormonal, apoya al sistema inmune, etc.
- También puede adminitrarse en animales sanos para mejorar su microbioma intestinal.
- Garantiza la supervivencia en el ambiente ácido del estómago.
- Se puede administrar con antibióticos.
- Es apto para todas las razas y todos los tamaños.
Instrucciones de uso:
Usa 1 cucharada (incluida en el envase) por cada 20 kg de peso corporal, dividide en dos tomas para obtener los mejores resultados.
1 cucharada = 5 g.
5 kg = ¼ cucharada diaria
10 kg = ½ cucharada diaria
20 kg = 1 cucharada diaria
40 kg = 2 cucharadas diarias
Estas son dosis de mantenimiento. Se recomienda duplicar la dosis diaria durante las primeras semanas mientras se controla la afección.
No exceda la dosis recomendada.
maxxidigest + no contiene sabores ni conservantes artificiales, solo ingredientes de primera calidad para ayudar a su mascota.
Sabor natural. Apto para todas las razas de perros. Fabricado en EE. UU. En instalaciones de fabricación certificadas por GMP y NASC (National Animal Supplement Council) que utilizan ingredientes de grado humano farmacéutico NO-GMO, probados en cuanto a pureza y potencia.
maxxidigest + se puede administrar con seguridad junto con otros medicamentos, incluidos los tratamientos con antibióticos. Comúnmente, se sabe que los tratamientos con antibióticos interrumpen la función probiótica adecuada tanto en perros como en humanos, lo que provoca malestar estomacal, infecciones del tracto gastrointestinal, como infecciones del tracto urinario e infecciones por hongos. Maxxidigest + fórmula prebiótica y probiótica permite una repoblación probiótica eficiente incluso en estos casos.
Ingredientes activos por cucharada:
Pediococcus acidilactici (Mito5051TM) (Mil millones de ufc) ........... 200 mg
L-glutamina ........................................................... 400 mg
Metilsulfonilmetano (MSM) ............................................. 400 mg
N-acetil-D-glucosamina ................................................ 300 mg
Fucus vesiculosus (algas marinas, planta entera, seca) ................. 50 mg
Bromelina (piña, tallo) ..................................... ( 120 GDU) 50 mg
Papain (Carica papaya, fruta) ............................. (80,000 USP) 40 mg
Pancrelipase (porcino, pancreas) ....................................... 20 mg
Estandarizado para contener:
Lipasa (24 USP / mg): 480 USP
Proteasa (100 USP / mg): 2,000 USP
Amilasa (100 USP / mg): 2,000 USP
Vitis vinifera (extracto de semilla de uva: 120: 1) .................... 25 mg
Equivalente a: 3,000 mg de semilla de uva.
Estandarizado a: 95% de proantocianidinas.
L-cistina .............................................................. 20 mg
L-taurina .............................................................. 10 mg
Cromo (polinicotinato) .................................................. 2 mcg
Biotina (Vitamina H) .................................................... 2 mcg
Ingredientes inactivos:harina de lino desgrasada, girasol y sésamo, dextrosa, lactosa, maltodextrina, dióxido de silicio.
Sabor natural: No contiene sabores, colores, conservantes ni aglutinantes artificiales.
Este envase contiene 200g de polvo.
Guardar en un lugar fresco y seco.
REFRIGERAR UNA VEZ ABIERTO.
INFORMACIÓN AMPLIADA DE INGREDIENTES:
Pediococcus Acidilactici (P. Acidilactici):
Probiótico específico para animales que sobrevive en el duro ambiente dentro del estómago de los perros y apoya la salud digestiva e inmunológica.
¿Qué es P. acidilactici?
Pediococcus es una bacteria beneficiosa que existe naturalmente en los tractos gastrointestinales (GI) humanos y animales. Su seguridad está probada. Pertenece a General Regarded As Safe (GRAS) desde la perspectiva del Departamento de Alimentos y Medicamentos de EE. UU. (FDA).
Los beneficios de P. acidilactici
- Probiótico específico para animales que sobrevive en el duro ambiente dentro del estómago de los perros
- Apoya la función digestiva y la salud inmunológica
¿Qué diferencia a P. acidilactici de otras bacterias probióticas?
En comparación con las bacterias probióticas convencionales (como Bifidobacterium y Lactobacillus), Pediococcus acidilactici es menos sensible a la exposición al oxígeno y a la temperatura elevada.
Pediococcus acidilactici puede sobrevivir a temperaturas de hasta 65 ° C y es capaz de crecer en condiciones aeróbicas y semi-aeróbicas.
Esto hace que Pediococcus acidilactici sea más estable como probiótico.
Además, debido a su resistencia al ambiente ácido, P. acidilactici es capaz de sobrevivir a la exposición al ácido del estómago de los perros y, por lo tanto, permite la entrega al tracto gastrointestinal para obtener los máximos efectos en la salud.
En pocas palabras, los probióticos no se tratan de cantidad sino de calidad. Necesita mucho menos volumen de Pediococcus acidilactici, ya que sobreviven al ácido del estómago y, por lo tanto, están garantizados para llegar al tracto gastrointestinal para obtener los máximos beneficios para la salud.
Lo mejor de las bacterias probióticas para perros.
La foto de abajo demuestra el avance que tiene Pediococcus acidilactici sobre las bacterias probióticas más convencionales. El ácido del estómago en nuestros perros y gatos es más ácido que en los humanos. Su nivel de pH está entre 1 y 2, pero un pH más bajo significa una mayor acidez (el pH de los humanos es 5 con el estómago lleno).
Como muestra la foto, solo Pediococcus acidilactici sobrevive al ambiente ácido en el estómago de nuestras mascotas. Esto es lo que hace que Pediococcus acidilactici sea la mejor bacteria probiótica para perros y gatos.
 Que Pediococcus acidilactici sea menos sensible a la exposición al oxígeno y a la temperatura elevada, también significa que maxxidigest + tiene una vida útil más larga que los probióticos convencionales.
Los estudios confirman que el pediococcus acidilactici funciona.
Los estudios han confirmado que Pediococcus acidilactici no solo es útil para aliviar los efectos secundarios de los medicamentos cuando se administra junto con el tratamiento con medicamentos. P. acidilactici también ayuda a perros y gatos a acelerar su recuperación de enfermedades agudas o crónicas.
"La investigación en animales ha demostrado que P. acidilactici es capaz de equilibrar la microflora intestinal y reducir el riesgo de una salud subóptima. Además, los resultados actuales indican que P. acidilactici es capaz de promover una respuesta inflamatoria saludable en los intestinos, así como apoyar una respuesta inmune saludable. P. acidilactici produce varios compuestos antimicrobianos diferentes que disminuyen el número de bacterias patógenas. Compite activamente contra Listeria "(Jarrow) *
* Las bacterias patógenas son bacterias que pueden causar infecciones.
L-glutamina (glutamina)
Repara la barrera mucosa intestinal dañada y ayuda a optimizar la función inmunológica
¿Qué es la glutamina?
Hay dos tipos de glutamina, pero toda la glutamina que se encuentra en los alimentos o suplementos es L-Glutamina.
La glutamina es un aminoácido no esencial (un componente básico de las proteínas) que se encuentra naturalmente en el cuerpo. Tiene muchas funciones de apoyo para el tracto digestivo.
La suplementación puede mejorar la salud digestiva y optimizar la función del sistema inmunológico (PetMD).
La glutamina sirve como fuente de energía primaria para las células de la mucosa que recubren el tracto intestinal. El estrés en las células intestinales puede aumentar la necesidad de glutamina, p. Ej. debido a enfermedades crónicas del intestino.
Los beneficios de la glutamina para perros:
La suplementación con glutamina se recomienda comúnmente para mascotas con trastornos intestinales agudos o crónicos, incluida la enfermedad inflamatoria intestinal, diarrea crónica, síndrome del intestino permeable y síndrome del intestino irritable.
- Repara la barrera de la mucosa intestinal dañada.
- Ayuda a optimizar la función inmunológica.
- Aminoácido no esencial para proteínas.
Cómo actúa la glutamina:
La L-glutamina construye y calma el tejido inflamatorio en el revestimiento intestinal. Repara la barrera de la mucosa intestinal dañada deteniendo la permeabilidad intestinal, la fuga de proteínas grandes al torrente sanguíneo. También puede conducir a una mejor absorción de nutrientes en el tracto intestinal.
La glutamina también puede reducir la toxicidad gastrointestinal de algunos medicamentos de quimioterapia y puede minimizar la inflamación del tracto intestinal causada por la radioterapia (Withrow y MacEwen's Small Animal Clinical Oncology).
Metilsulfonilmetano (MSM)
Combate eficazmente las inflamaciones resultantes de reacciones autoinmunes y puede ser útil como alivio de alergias.
¿Qué es MSM?
El MSM es la fuente de azufre en el cuerpo.
Quizás sea más conocido por su papel en el apoyo a la salud de las articulaciones, pero los HSH ofrecen otros beneficios para la salud.
Los beneficios del MSM para perros:
- Ayuda a mantener el tejido conectivo sano.
- Apoya el alivio de las reacciones alérgicas.
- Aborda la inflamación resultante de reacciones autoinmunes.
Cómo funciona MSM para perros:
El MSM mantiene el tejido conectivo sano y tiene propiedades antiinflamatorias y dolorosas naturales.
Combate eficazmente las inflamaciones resultantes de reacciones autoinmunes (en las que el sistema inmunológico del cuerpo se activa) y también puede ser útil como alivio de las alergias.
N-acetil-D-glucosamina (NAG):
Ayuda a mantener la permeabilidad intestinal normal al proteger el revestimiento del estómago y los intestinos.
¿Qué es la N-acetil-D-glucosamina?
La glucosamina se presenta en diferentes formas.
La glucosamina HCL y el sulfato de glucosamina son los más conocidos, pero se utilizan comúnmente en suplementos para articulaciones de calidad para perros, como maxxiflex +.
La N-acetil-D-glucosamina, o NAG, es una forma más de glucosamina y se encuentra en la capa exterior de los mariscos.
Los beneficios de NAG para perros:
- Protege el revestimiento del estómago y los intestinos.
- Sulfato que se encuentra en los mariscos.
- Comúnmente tomado para la osteoartritis y enfermedades inflamatorias del intestino.
Cómo funciona:
NAG ayuda a proteger el revestimiento del estómago y los intestinos, es decir, ayuda a mantener la permeabilidad intestinal normal.
La N-acetil-D-glucosamina se toma comúnmente para la osteoartritis y la enfermedad inflamatoria intestinal (EII), incluidas la colitis ulcerosa y la enfermedad de Crohn (PetMD).
Fucus Vesiculosus:
Apoya la función y el metabolismo saludables de la tiroides.
¿Qué es el fucus vesiculosus?
Fucus vesiculosus (también conocido como fucus) es un alga (alga marina) que crece en océanos más fríos en todo el mundo.
Las algas están llenas de nutrientes. Contiene yodo, que se usa para prevenir y tratar algunos trastornos de la tiroides. También proporciona hierro, B12 energizante y fibra dietética, junto con folato (ácido fólico) y riboflavina.
Los beneficios del fucus vesiculosus:
- Yodo natural para el apoyo de la tiroides.
- Aporta hierro, B12, ácido fólico y riboflavina.
- Apoya la función y el metabolismo saludables de la tiroides.
Cómo funciona:
"Ese perfil nutricional sugiere que las algas marinas podrían ayudar a elevar los niveles de energía. El magnesio y la fibra de las algas te ayudarán a evitar el estreñimiento. Algunas pruebas médicas sugieren que las algas pardas pueden combatir algunos cánceres e infecciones" (Healthline).
En pocas palabras, el fucus vesiculosus favorece la función y el metabolismo saludables de la tiroides.
Bromelina:
Auxiliar digestivo de proteínas y antihistamínico natural.
¿Qué es la bromelina?
La bromelina es una enzima natural procedente de la piña.
Se utiliza principalmente para aliviar el dolor y la hinchazón, por lo que encontrará bromelina en nuestro suplemento para articulaciones de perro maxxiflex +.
Pero eso no es todo. La bromelina también ayuda con muchos problemas digestivos.
Los beneficios de la bromelina:
- antihistamínico natural.
- Ayuda digestiva para proteínas.
Cómo funciona:
Los fluidos digestivos en el sistema de nuestro perro y gato destruyen la mayoría de las enzimas ingeridas por vía oral antes de que sean absorbidas. Sin embargo, la bromelina es una enzima proteolítica, es decir, tiene la capacidad de descomponer proteínas.
Esto significa que la bromelina puede ayudar al cuerpo a digerir los alimentos y absorber los nutrientes de manera más eficiente, así como a curar de manera efectiva varios problemas en el tracto gastrointestinal.
La bromelina también es un antihistamínico natural, es decir, digiere la molécula de histamina. La histamina causa alergias, por lo que la bromelina puede ayudar a aliviar algunos de los síntomas de alergia más comunes.
Papaína:
Ayuda digestiva y analgésica natural.
¿Qué es la papaína?
La papaína es otra enzima digestiva popular y funciona de manera similar a la bromelina para apoyar la salud digestiva de nuestras mascotas.
También se ha demostrado que la papaína es tan eficaz como la aspirina como agente analgésico y antiinflamatorio en una variedad de afecciones médicas.
La papaya y la piña son dos de las fuentes vegetales más ricas en enzimas digestivas. La papaína y la bromelina son los nombres respectivos de las enzimas proteolíticas que se encuentran en estas frutas.
Los beneficios de la papaína para perros:
- Ayuda digestiva.
- Alivio natural del dolor.
Cómo funciona:
El uso principal de las enzimas proteolíticas (como la papaína y la bromelina) es como ayuda digestiva.
Las enzimas digestivas pueden ayudar a evitar este problema llamado "intestino permeable". Pueden ser útiles para una amplia variedad de otras afecciones de salud, especialmente alergias alimentarias (presumiblemente al digerir la comida tan bien que hay menos a qué ser alérgico), dermatitis atópica (alérgica), bolas de pelo, artritis, enfermedad inflamatoria intestinal y autoinmune enfermedades.
Pancrelipasa:
Apoya la función pancreática y es crucial para una digestión normal.
¿Qué es la pancrelipasa?
La pancrelipasa es una combinación de tres enzimas (proteínas): lipasa, proteasa y amilasa. Estas enzimas son normalmente producidas por el páncreas y son cruciales para una digestión normal.
La pancrelipasa se usa para reemplazar estas enzimas cuando el cuerpo no tiene suficiente.
La pancrelipasa se elabora a partir del páncreas de los cerdos.
Los beneficios de la pancrelipasa:
- Combinación de tres enzimas producidas por el páncreas que son cruciales para la digestión normal.
- Mejora la función pancreática.
- Ofrecer apoyo para los trastornos pancreáticos.
- Ayuda en el procesamiento de carbohidratos, grasas y proteínas.
Cómo funciona:
La pancrelipasa mejora la función pancreática (ayuda al páncreas a descomponer los carbohidratos, las grasas y las proteínas).
Se utiliza para tratar trastornos pancreáticos en mascotas, incluida la insuficiencia pancreática exocrina (EPI) en perros y gatos. La EPI causa una incapacidad para digerir los alimentos normalmente y generalmente es el resultado de episodios repetidos de pancreatitis.
maxxidigest + comienza apoyando el páncreas con pancrelipasa que ayuda a descomponer todos los alimentos ingeridos, incluso los alimentos no tan buenos (altos en carbohidratos).
La pancrelipasa proporciona tres enzimas, lipasa para grasas, amilasa para carbohidratos y proteasa para la digestión de proteínas esenciales para la digestión y absorción de numerosos nutrientes, especialmente grasas.
Vitis vinifera:
Antioxidante, antiinflamatorio y antialérgico.
¿Qué es la vitis vinifera?
Como todos los dueños de perros saben, las uvas pueden ser tóxicas para nuestros perros (no hay informes de gatos que se enfermen a causa de las uvas, pero es poco probable que las coman).
Sin embargo, el extracto de semilla de uva (vitis vinifera) y el aceite de la uva no son tóxicos y ofrecen importantes beneficios para la salud tanto de perros como de gatos.
El extracto de semilla de uva se elabora a partir de las semillas trituradas de la uva (un subproducto de la industria vinícola).
Los beneficios de la vitis vinifera para perros:
- Extracción no tóxica para suplementos.
- Antiinflamatorio.
- Antialérgico.
- antioxidante.
Cómo funciona:
Vitis vinifera contiene ingredientes antiinflamatorios, antialérgicos y antioxidantes.
Lo que lo convierte en un buen ingrediente en una fórmula digestiva e inmunológica avanzada como maxxidigest +.
L-cistina:
Apoya la síntesis de proteínas
¿Qué es la cistina?
La cistina no es lo mismo que la cisteína, pero ambos son aminoácidos.
La cistina juega un papel importante en la síntesis de proteínas; ayuda a determinar la forma final de la proteína.
Los beneficios de la cistina para perros:
- Apoya la síntesis de proteínas.
- Aumenta la eliminación de grasa del torrente sanguíneo.
Cómo funciona:
Los estudios en ratas muestran que la cistina aumenta los niveles de una enzima que elimina las grasas del torrente sanguíneo.
L-taurina:
Ayuda a regular los niveles de agua y sodio en sangre y tiene un efecto calmante.
¿Qué es la taurina?
La taurina es un aminoácido que apoya el desarrollo neurológico, ayuda a regular el nivel de agua y sales minerales en la sangre y tiene propiedades antioxidantes.
Se ha demostrado que la taurina es beneficiosa para la función cardíaca, pero tiene muchos otros beneficios, incluido el efecto calmante y estabilizador en el cerebro (por lo que es uno de los ingredientes clave de nuestra ayuda calmante para perros, maxxicalm).
Los beneficios de la taurina para perros:
- Ayuda a regular los niveles de agua y sodio en sangre.
- Beneficioso para la función cardíaca.
- Tiene un efecto calmante natural sobre la función cerebral.
Deficiencia de taurina:
Los perros pueden sufrir deficiencia de taurina, es decir, si el cuerpo no produce suficiente.
"La taurina se encuentra principalmente en la carne de los músculos y está completamente ausente en los cereales. La falta de taurina en la dieta provocó el desarrollo de graves enfermedades oculares y cardíacas".
¿Qué es el cromo?
El cromo (polinicotinato) es un oligoelemento (metal) que ayuda a mantener normales los niveles de azúcar en la sangre al mejorar la forma en que el cuerpo usa la insulina.
La suplementación con cromo puede ayudar a perder grasa corporal, retener y desarrollar masa corporal magra, disminuir los niveles elevados de azúcar en sangre y reducir los niveles de colesterol en sangre.
Cromo:
Ayuda a controlar los niveles de azúcar y colesterol en sangre.
Los beneficios del cromo para perros:
- Ayuda a perder grasa.
- Ayuda a controlar los niveles de azúcar y colesterol en sangre.
- Estudiado en mascotas tanto para perder peso como para regular la glucosa.
Cómo funciona:
El efecto del cromo en perros y gatos se ha estudiado tanto para la pérdida de peso como para la regulación de la glucosa en diabéticos.
El cromo puede ser útil en animales diabéticos que son difíciles de regular con insulina.
Biotina:
Requerido para el correcto funcionamiento de las enzimas en el cuerpo.
¿Qué es la biotina?
La biotina (o vitamina H o B7) es una de las ocho vitaminas que se encuentran en el complejo B.
Los beneficios de la biotina para perros:
- Apoya la función enzimática.
- Ayuda a mantener la piel y el cabello sanos.
Cómo funciona:
Además de ayudar a mantener la piel y el cabello saludables (además de nuestro Pet Factor Omega 3), la biotina es necesaria para el correcto funcionamiento de las enzimas del cuerpo.
Base en polvo:
Contiene prebióticos vitales y ayuda con la digestión y muchas afecciones relacionadas con el tracto gastrointestinal (GI).
¿Qué hay en la base en polvo?
La base en polvo utilizada en maxxidigest + contiene fibra de lino desgrasada, girasol y semillas de sésamo que también proporciona propiedades inmunológicas y de función hormonal.
Esta es una forma concentrada de fibra que proporciona casi el doble del contenido de lignanos que la harina de lino integral.
La base de maxxidigest + no solo llena, tiene sus propios beneficios para la salud de los perros.
Los lignanos tienen propiedades de equilibrio hormonal:
Los lignanos son un grupo de compuestos químicos que se encuentran en las plantas. Los lignanos son ricos en antioxidantes y fibra, y tienen efectos antiestrogénicos, es decir, pueden ayudar a regular los niveles hormonales.
Lignanos ofrece diversos beneficios para la salud de nuestros perros. Al tener un alto contenido de antioxidantes, apoyan el sistema inmunológico. Si bien las propiedades de equilibrio hormonal de los lignanos significan que son beneficiosos tanto para los animales machos como para las hembras que han sido esterilizados o castrados.
Pero eso no es todo, la base de maxxidigest + también contiene prebióticos vitales
Los beneficios de la base en polvo:
- Los prebióticos son vitales para la supervivencia de los probióticos.
- Ayuda con la digestión y muchas afecciones relacionadas con el tracto gastrointestinal.
- Apoya el sistema inmunológico.
- Ofrecer apoyo para la función hormonal adecuada.
¿Cómo funcionan los prebióticos para los perros?:
La fibra ayuda con la digestión y muchas afecciones relacionadas con el tracto gastrointestinal (GI).
Pediococcus acidilactici es el mejor probiótico para mascotas, pero se necesitan prebióticos para alimentar a los probióticos.
"Los probióticos son bacterias" buenas "que ayudan a mantener su sistema digestivo saludable controlando el crecimiento de bacterias dañinas. Los prebióticos son carbohidratos que el cuerpo humano no puede digerir. Son alimento para los probióticos. El beneficio principal de los probióticos y prebióticos parece estar ayudando mantienes un sistema digestivo saludable".
Esta es una cosa más que hace que maxxidigest + sea diferente de las otras fórmulas digestivas que existen.
Al poner los ingredientes medicinales digestivos y reconstituyentes en una base de fibra de semilla desgrasada a base de lino, girasol y sésamo (los prebióticos) estamos mejorando la función inmunológica al alimentar la flora intestinal de los perros. Al hacerlo, las bacterias prosperarán, limpiarán el medio ambiente y permitirán una mejor absorción de los ingredientes medicinales de la fórmula, así como de la comida de los animales.
Que Pediococcus acidilactici sea menos sensible a la exposición al oxígeno y a la temperatura elevada, también significa que maxxidigest + tiene una vida útil más larga que los probióticos convencionales.
Los estudios confirman que el pediococcus acidilactici funciona.
Los estudios han confirmado que Pediococcus acidilactici no solo es útil para aliviar los efectos secundarios de los medicamentos cuando se administra junto con el tratamiento con medicamentos. P. acidilactici también ayuda a perros y gatos a acelerar su recuperación de enfermedades agudas o crónicas.
"La investigación en animales ha demostrado que P. acidilactici es capaz de equilibrar la microflora intestinal y reducir el riesgo de una salud subóptima. Además, los resultados actuales indican que P. acidilactici es capaz de promover una respuesta inflamatoria saludable en los intestinos, así como apoyar una respuesta inmune saludable. P. acidilactici produce varios compuestos antimicrobianos diferentes que disminuyen el número de bacterias patógenas. Compite activamente contra Listeria "(Jarrow) *
* Las bacterias patógenas son bacterias que pueden causar infecciones.
L-glutamina (glutamina)
Repara la barrera mucosa intestinal dañada y ayuda a optimizar la función inmunológica
¿Qué es la glutamina?
Hay dos tipos de glutamina, pero toda la glutamina que se encuentra en los alimentos o suplementos es L-Glutamina.
La glutamina es un aminoácido no esencial (un componente básico de las proteínas) que se encuentra naturalmente en el cuerpo. Tiene muchas funciones de apoyo para el tracto digestivo.
La suplementación puede mejorar la salud digestiva y optimizar la función del sistema inmunológico (PetMD).
La glutamina sirve como fuente de energía primaria para las células de la mucosa que recubren el tracto intestinal. El estrés en las células intestinales puede aumentar la necesidad de glutamina, p. Ej. debido a enfermedades crónicas del intestino.
Los beneficios de la glutamina para perros:
La suplementación con glutamina se recomienda comúnmente para mascotas con trastornos intestinales agudos o crónicos, incluida la enfermedad inflamatoria intestinal, diarrea crónica, síndrome del intestino permeable y síndrome del intestino irritable.
- Repara la barrera de la mucosa intestinal dañada.
- Ayuda a optimizar la función inmunológica.
- Aminoácido no esencial para proteínas.
Cómo actúa la glutamina:
La L-glutamina construye y calma el tejido inflamatorio en el revestimiento intestinal. Repara la barrera de la mucosa intestinal dañada deteniendo la permeabilidad intestinal, la fuga de proteínas grandes al torrente sanguíneo. También puede conducir a una mejor absorción de nutrientes en el tracto intestinal.
La glutamina también puede reducir la toxicidad gastrointestinal de algunos medicamentos de quimioterapia y puede minimizar la inflamación del tracto intestinal causada por la radioterapia (Withrow y MacEwen's Small Animal Clinical Oncology).
Metilsulfonilmetano (MSM)
Combate eficazmente las inflamaciones resultantes de reacciones autoinmunes y puede ser útil como alivio de alergias.
¿Qué es MSM?
El MSM es la fuente de azufre en el cuerpo.
Quizás sea más conocido por su papel en el apoyo a la salud de las articulaciones, pero los HSH ofrecen otros beneficios para la salud.
Los beneficios del MSM para perros:
- Ayuda a mantener el tejido conectivo sano.
- Apoya el alivio de las reacciones alérgicas.
- Aborda la inflamación resultante de reacciones autoinmunes.
Cómo funciona MSM para perros:
El MSM mantiene el tejido conectivo sano y tiene propiedades antiinflamatorias y dolorosas naturales.
Combate eficazmente las inflamaciones resultantes de reacciones autoinmunes (en las que el sistema inmunológico del cuerpo se activa) y también puede ser útil como alivio de las alergias.
N-acetil-D-glucosamina (NAG):
Ayuda a mantener la permeabilidad intestinal normal al proteger el revestimiento del estómago y los intestinos.
¿Qué es la N-acetil-D-glucosamina?
La glucosamina se presenta en diferentes formas.
La glucosamina HCL y el sulfato de glucosamina son los más conocidos, pero se utilizan comúnmente en suplementos para articulaciones de calidad para perros, como maxxiflex +.
La N-acetil-D-glucosamina, o NAG, es una forma más de glucosamina y se encuentra en la capa exterior de los mariscos.
Los beneficios de NAG para perros:
- Protege el revestimiento del estómago y los intestinos.
- Sulfato que se encuentra en los mariscos.
- Comúnmente tomado para la osteoartritis y enfermedades inflamatorias del intestino.
Cómo funciona:
NAG ayuda a proteger el revestimiento del estómago y los intestinos, es decir, ayuda a mantener la permeabilidad intestinal normal.
La N-acetil-D-glucosamina se toma comúnmente para la osteoartritis y la enfermedad inflamatoria intestinal (EII), incluidas la colitis ulcerosa y la enfermedad de Crohn (PetMD).
Fucus Vesiculosus:
Apoya la función y el metabolismo saludables de la tiroides.
¿Qué es el fucus vesiculosus?
Fucus vesiculosus (también conocido como fucus) es un alga (alga marina) que crece en océanos más fríos en todo el mundo.
Las algas están llenas de nutrientes. Contiene yodo, que se usa para prevenir y tratar algunos trastornos de la tiroides. También proporciona hierro, B12 energizante y fibra dietética, junto con folato (ácido fólico) y riboflavina.
Los beneficios del fucus vesiculosus:
- Yodo natural para el apoyo de la tiroides.
- Aporta hierro, B12, ácido fólico y riboflavina.
- Apoya la función y el metabolismo saludables de la tiroides.
Cómo funciona:
"Ese perfil nutricional sugiere que las algas marinas podrían ayudar a elevar los niveles de energía. El magnesio y la fibra de las algas te ayudarán a evitar el estreñimiento. Algunas pruebas médicas sugieren que las algas pardas pueden combatir algunos cánceres e infecciones" (Healthline).
En pocas palabras, el fucus vesiculosus favorece la función y el metabolismo saludables de la tiroides.
Bromelina:
Auxiliar digestivo de proteínas y antihistamínico natural.
¿Qué es la bromelina?
La bromelina es una enzima natural procedente de la piña.
Se utiliza principalmente para aliviar el dolor y la hinchazón, por lo que encontrará bromelina en nuestro suplemento para articulaciones de perro maxxiflex +.
Pero eso no es todo. La bromelina también ayuda con muchos problemas digestivos.
Los beneficios de la bromelina:
- antihistamínico natural.
- Ayuda digestiva para proteínas.
Cómo funciona:
Los fluidos digestivos en el sistema de nuestro perro y gato destruyen la mayoría de las enzimas ingeridas por vía oral antes de que sean absorbidas. Sin embargo, la bromelina es una enzima proteolítica, es decir, tiene la capacidad de descomponer proteínas.
Esto significa que la bromelina puede ayudar al cuerpo a digerir los alimentos y absorber los nutrientes de manera más eficiente, así como a curar de manera efectiva varios problemas en el tracto gastrointestinal.
La bromelina también es un antihistamínico natural, es decir, digiere la molécula de histamina. La histamina causa alergias, por lo que la bromelina puede ayudar a aliviar algunos de los síntomas de alergia más comunes.
Papaína:
Ayuda digestiva y analgésica natural.
¿Qué es la papaína?
La papaína es otra enzima digestiva popular y funciona de manera similar a la bromelina para apoyar la salud digestiva de nuestras mascotas.
También se ha demostrado que la papaína es tan eficaz como la aspirina como agente analgésico y antiinflamatorio en una variedad de afecciones médicas.
La papaya y la piña son dos de las fuentes vegetales más ricas en enzimas digestivas. La papaína y la bromelina son los nombres respectivos de las enzimas proteolíticas que se encuentran en estas frutas.
Los beneficios de la papaína para perros:
- Ayuda digestiva.
- Alivio natural del dolor.
Cómo funciona:
El uso principal de las enzimas proteolíticas (como la papaína y la bromelina) es como ayuda digestiva.
Las enzimas digestivas pueden ayudar a evitar este problema llamado "intestino permeable". Pueden ser útiles para una amplia variedad de otras afecciones de salud, especialmente alergias alimentarias (presumiblemente al digerir la comida tan bien que hay menos a qué ser alérgico), dermatitis atópica (alérgica), bolas de pelo, artritis, enfermedad inflamatoria intestinal y autoinmune enfermedades.
Pancrelipasa:
Apoya la función pancreática y es crucial para una digestión normal.
¿Qué es la pancrelipasa?
La pancrelipasa es una combinación de tres enzimas (proteínas): lipasa, proteasa y amilasa. Estas enzimas son normalmente producidas por el páncreas y son cruciales para una digestión normal.
La pancrelipasa se usa para reemplazar estas enzimas cuando el cuerpo no tiene suficiente.
La pancrelipasa se elabora a partir del páncreas de los cerdos.
Los beneficios de la pancrelipasa:
- Combinación de tres enzimas producidas por el páncreas que son cruciales para la digestión normal.
- Mejora la función pancreática.
- Ofrecer apoyo para los trastornos pancreáticos.
- Ayuda en el procesamiento de carbohidratos, grasas y proteínas.
Cómo funciona:
La pancrelipasa mejora la función pancreática (ayuda al páncreas a descomponer los carbohidratos, las grasas y las proteínas).
Se utiliza para tratar trastornos pancreáticos en mascotas, incluida la insuficiencia pancreática exocrina (EPI) en perros y gatos. La EPI causa una incapacidad para digerir los alimentos normalmente y generalmente es el resultado de episodios repetidos de pancreatitis.
maxxidigest + comienza apoyando el páncreas con pancrelipasa que ayuda a descomponer todos los alimentos ingeridos, incluso los alimentos no tan buenos (altos en carbohidratos).
La pancrelipasa proporciona tres enzimas, lipasa para grasas, amilasa para carbohidratos y proteasa para la digestión de proteínas esenciales para la digestión y absorción de numerosos nutrientes, especialmente grasas.
Vitis vinifera:
Antioxidante, antiinflamatorio y antialérgico.
¿Qué es la vitis vinifera?
Como todos los dueños de perros saben, las uvas pueden ser tóxicas para nuestros perros (no hay informes de gatos que se enfermen a causa de las uvas, pero es poco probable que las coman).
Sin embargo, el extracto de semilla de uva (vitis vinifera) y el aceite de la uva no son tóxicos y ofrecen importantes beneficios para la salud tanto de perros como de gatos.
El extracto de semilla de uva se elabora a partir de las semillas trituradas de la uva (un subproducto de la industria vinícola).
Los beneficios de la vitis vinifera para perros:
- Extracción no tóxica para suplementos.
- Antiinflamatorio.
- Antialérgico.
- antioxidante.
Cómo funciona:
Vitis vinifera contiene ingredientes antiinflamatorios, antialérgicos y antioxidantes.
Lo que lo convierte en un buen ingrediente en una fórmula digestiva e inmunológica avanzada como maxxidigest +.
L-cistina:
Apoya la síntesis de proteínas
¿Qué es la cistina?
La cistina no es lo mismo que la cisteína, pero ambos son aminoácidos.
La cistina juega un papel importante en la síntesis de proteínas; ayuda a determinar la forma final de la proteína.
Los beneficios de la cistina para perros:
- Apoya la síntesis de proteínas.
- Aumenta la eliminación de grasa del torrente sanguíneo.
Cómo funciona:
Los estudios en ratas muestran que la cistina aumenta los niveles de una enzima que elimina las grasas del torrente sanguíneo.
L-taurina:
Ayuda a regular los niveles de agua y sodio en sangre y tiene un efecto calmante.
¿Qué es la taurina?
La taurina es un aminoácido que apoya el desarrollo neurológico, ayuda a regular el nivel de agua y sales minerales en la sangre y tiene propiedades antioxidantes.
Se ha demostrado que la taurina es beneficiosa para la función cardíaca, pero tiene muchos otros beneficios, incluido el efecto calmante y estabilizador en el cerebro (por lo que es uno de los ingredientes clave de nuestra ayuda calmante para perros, maxxicalm).
Los beneficios de la taurina para perros:
- Ayuda a regular los niveles de agua y sodio en sangre.
- Beneficioso para la función cardíaca.
- Tiene un efecto calmante natural sobre la función cerebral.
Deficiencia de taurina:
Los perros pueden sufrir deficiencia de taurina, es decir, si el cuerpo no produce suficiente.
"La taurina se encuentra principalmente en la carne de los músculos y está completamente ausente en los cereales. La falta de taurina en la dieta provocó el desarrollo de graves enfermedades oculares y cardíacas".
¿Qué es el cromo?
El cromo (polinicotinato) es un oligoelemento (metal) que ayuda a mantener normales los niveles de azúcar en la sangre al mejorar la forma en que el cuerpo usa la insulina.
La suplementación con cromo puede ayudar a perder grasa corporal, retener y desarrollar masa corporal magra, disminuir los niveles elevados de azúcar en sangre y reducir los niveles de colesterol en sangre.
Cromo:
Ayuda a controlar los niveles de azúcar y colesterol en sangre.
Los beneficios del cromo para perros:
- Ayuda a perder grasa.
- Ayuda a controlar los niveles de azúcar y colesterol en sangre.
- Estudiado en mascotas tanto para perder peso como para regular la glucosa.
Cómo funciona:
El efecto del cromo en perros y gatos se ha estudiado tanto para la pérdida de peso como para la regulación de la glucosa en diabéticos.
El cromo puede ser útil en animales diabéticos que son difíciles de regular con insulina.
Biotina:
Requerido para el correcto funcionamiento de las enzimas en el cuerpo.
¿Qué es la biotina?
La biotina (o vitamina H o B7) es una de las ocho vitaminas que se encuentran en el complejo B.
Los beneficios de la biotina para perros:
- Apoya la función enzimática.
- Ayuda a mantener la piel y el cabello sanos.
Cómo funciona:
Además de ayudar a mantener la piel y el cabello saludables (además de nuestro Pet Factor Omega 3), la biotina es necesaria para el correcto funcionamiento de las enzimas del cuerpo.
Base en polvo:
Contiene prebióticos vitales y ayuda con la digestión y muchas afecciones relacionadas con el tracto gastrointestinal (GI).
¿Qué hay en la base en polvo?
La base en polvo utilizada en maxxidigest + contiene fibra de lino desgrasada, girasol y semillas de sésamo que también proporciona propiedades inmunológicas y de función hormonal.
Esta es una forma concentrada de fibra que proporciona casi el doble del contenido de lignanos que la harina de lino integral.
La base de maxxidigest + no solo llena, tiene sus propios beneficios para la salud de los perros.
Los lignanos tienen propiedades de equilibrio hormonal:
Los lignanos son un grupo de compuestos químicos que se encuentran en las plantas. Los lignanos son ricos en antioxidantes y fibra, y tienen efectos antiestrogénicos, es decir, pueden ayudar a regular los niveles hormonales.
Lignanos ofrece diversos beneficios para la salud de nuestros perros. Al tener un alto contenido de antioxidantes, apoyan el sistema inmunológico. Si bien las propiedades de equilibrio hormonal de los lignanos significan que son beneficiosos tanto para los animales machos como para las hembras que han sido esterilizados o castrados.
Pero eso no es todo, la base de maxxidigest + también contiene prebióticos vitales
Los beneficios de la base en polvo:
- Los prebióticos son vitales para la supervivencia de los probióticos.
- Ayuda con la digestión y muchas afecciones relacionadas con el tracto gastrointestinal.
- Apoya el sistema inmunológico.
- Ofrecer apoyo para la función hormonal adecuada.
¿Cómo funcionan los prebióticos para los perros?:
La fibra ayuda con la digestión y muchas afecciones relacionadas con el tracto gastrointestinal (GI).
Pediococcus acidilactici es el mejor probiótico para mascotas, pero se necesitan prebióticos para alimentar a los probióticos.
"Los probióticos son bacterias" buenas "que ayudan a mantener su sistema digestivo saludable controlando el crecimiento de bacterias dañinas. Los prebióticos son carbohidratos que el cuerpo humano no puede digerir. Son alimento para los probióticos. El beneficio principal de los probióticos y prebióticos parece estar ayudando mantienes un sistema digestivo saludable".
Esta es una cosa más que hace que maxxidigest + sea diferente de las otras fórmulas digestivas que existen.
Al poner los ingredientes medicinales digestivos y reconstituyentes en una base de fibra de semilla desgrasada a base de lino, girasol y sésamo (los prebióticos) estamos mejorando la función inmunológica al alimentar la flora intestinal de los perros. Al hacerlo, las bacterias prosperarán, limpiarán el medio ambiente y permitirán una mejor absorción de los ingredientes medicinales de la fórmula, así como de la comida de los animales.
Que Pediococcus acidilactici sea menos sensible a la exposición al oxígeno y a la temperatura elevada, también significa que maxxidigest + tiene una vida útil más larga que los probióticos convencionales.
Los estudios confirman que el pediococcus acidilactici funciona.
Los estudios han confirmado que Pediococcus acidilactici no solo es útil para aliviar los efectos secundarios de los medicamentos cuando se administra junto con el tratamiento con medicamentos. P. acidilactici también ayuda a perros y gatos a acelerar su recuperación de enfermedades agudas o crónicas.
"La investigación en animales ha demostrado que P. acidilactici es capaz de equilibrar la microflora intestinal y reducir el riesgo de una salud subóptima. Además, los resultados actuales indican que P. acidilactici es capaz de promover una respuesta inflamatoria saludable en los intestinos, así como apoyar una respuesta inmune saludable. P. acidilactici produce varios compuestos antimicrobianos diferentes que disminuyen el número de bacterias patógenas. Compite activamente contra Listeria "(Jarrow) *
* Las bacterias patógenas son bacterias que pueden causar infecciones.
L-glutamina (glutamina)
Repara la barrera mucosa intestinal dañada y ayuda a optimizar la función inmunológica
¿Qué es la glutamina?
Hay dos tipos de glutamina, pero toda la glutamina que se encuentra en los alimentos o suplementos es L-Glutamina.
La glutamina es un aminoácido no esencial (un componente básico de las proteínas) que se encuentra naturalmente en el cuerpo. Tiene muchas funciones de apoyo para el tracto digestivo.
La suplementación puede mejorar la salud digestiva y optimizar la función del sistema inmunológico (PetMD).
La glutamina sirve como fuente de energía primaria para las células de la mucosa que recubren el tracto intestinal. El estrés en las células intestinales puede aumentar la necesidad de glutamina, p. Ej. debido a enfermedades crónicas del intestino.
Los beneficios de la glutamina para perros:
La suplementación con glutamina se recomienda comúnmente para mascotas con trastornos intestinales agudos o crónicos, incluida la enfermedad inflamatoria intestinal, diarrea crónica, síndrome del intestino permeable y síndrome del intestino irritable.
- Repara la barrera de la mucosa intestinal dañada.
- Ayuda a optimizar la función inmunológica.
- Aminoácido no esencial para proteínas.
Cómo actúa la glutamina:
La L-glutamina construye y calma el tejido inflamatorio en el revestimiento intestinal. Repara la barrera de la mucosa intestinal dañada deteniendo la permeabilidad intestinal, la fuga de proteínas grandes al torrente sanguíneo. También puede conducir a una mejor absorción de nutrientes en el tracto intestinal.
La glutamina también puede reducir la toxicidad gastrointestinal de algunos medicamentos de quimioterapia y puede minimizar la inflamación del tracto intestinal causada por la radioterapia (Withrow y MacEwen's Small Animal Clinical Oncology).
Metilsulfonilmetano (MSM)
Combate eficazmente las inflamaciones resultantes de reacciones autoinmunes y puede ser útil como alivio de alergias.
¿Qué es MSM?
El MSM es la fuente de azufre en el cuerpo.
Quizás sea más conocido por su papel en el apoyo a la salud de las articulaciones, pero los HSH ofrecen otros beneficios para la salud.
Los beneficios del MSM para perros:
- Ayuda a mantener el tejido conectivo sano.
- Apoya el alivio de las reacciones alérgicas.
- Aborda la inflamación resultante de reacciones autoinmunes.
Cómo funciona MSM para perros:
El MSM mantiene el tejido conectivo sano y tiene propiedades antiinflamatorias y dolorosas naturales.
Combate eficazmente las inflamaciones resultantes de reacciones autoinmunes (en las que el sistema inmunológico del cuerpo se activa) y también puede ser útil como alivio de las alergias.
N-acetil-D-glucosamina (NAG):
Ayuda a mantener la permeabilidad intestinal normal al proteger el revestimiento del estómago y los intestinos.
¿Qué es la N-acetil-D-glucosamina?
La glucosamina se presenta en diferentes formas.
La glucosamina HCL y el sulfato de glucosamina son los más conocidos, pero se utilizan comúnmente en suplementos para articulaciones de calidad para perros, como maxxiflex +.
La N-acetil-D-glucosamina, o NAG, es una forma más de glucosamina y se encuentra en la capa exterior de los mariscos.
Los beneficios de NAG para perros:
- Protege el revestimiento del estómago y los intestinos.
- Sulfato que se encuentra en los mariscos.
- Comúnmente tomado para la osteoartritis y enfermedades inflamatorias del intestino.
Cómo funciona:
NAG ayuda a proteger el revestimiento del estómago y los intestinos, es decir, ayuda a mantener la permeabilidad intestinal normal.
La N-acetil-D-glucosamina se toma comúnmente para la osteoartritis y la enfermedad inflamatoria intestinal (EII), incluidas la colitis ulcerosa y la enfermedad de Crohn (PetMD).
Fucus Vesiculosus:
Apoya la función y el metabolismo saludables de la tiroides.
¿Qué es el fucus vesiculosus?
Fucus vesiculosus (también conocido como fucus) es un alga (alga marina) que crece en océanos más fríos en todo el mundo.
Las algas están llenas de nutrientes. Contiene yodo, que se usa para prevenir y tratar algunos trastornos de la tiroides. También proporciona hierro, B12 energizante y fibra dietética, junto con folato (ácido fólico) y riboflavina.
Los beneficios del fucus vesiculosus:
- Yodo natural para el apoyo de la tiroides.
- Aporta hierro, B12, ácido fólico y riboflavina.
- Apoya la función y el metabolismo saludables de la tiroides.
Cómo funciona:
"Ese perfil nutricional sugiere que las algas marinas podrían ayudar a elevar los niveles de energía. El magnesio y la fibra de las algas te ayudarán a evitar el estreñimiento. Algunas pruebas médicas sugieren que las algas pardas pueden combatir algunos cánceres e infecciones" (Healthline).
En pocas palabras, el fucus vesiculosus favorece la función y el metabolismo saludables de la tiroides.
Bromelina:
Auxiliar digestivo de proteínas y antihistamínico natural.
¿Qué es la bromelina?
La bromelina es una enzima natural procedente de la piña.
Se utiliza principalmente para aliviar el dolor y la hinchazón, por lo que encontrará bromelina en nuestro suplemento para articulaciones de perro maxxiflex +.
Pero eso no es todo. La bromelina también ayuda con muchos problemas digestivos.
Los beneficios de la bromelina:
- antihistamínico natural.
- Ayuda digestiva para proteínas.
Cómo funciona:
Los fluidos digestivos en el sistema de nuestro perro y gato destruyen la mayoría de las enzimas ingeridas por vía oral antes de que sean absorbidas. Sin embargo, la bromelina es una enzima proteolítica, es decir, tiene la capacidad de descomponer proteínas.
Esto significa que la bromelina puede ayudar al cuerpo a digerir los alimentos y absorber los nutrientes de manera más eficiente, así como a curar de manera efectiva varios problemas en el tracto gastrointestinal.
La bromelina también es un antihistamínico natural, es decir, digiere la molécula de histamina. La histamina causa alergias, por lo que la bromelina puede ayudar a aliviar algunos de los síntomas de alergia más comunes.
Papaína:
Ayuda digestiva y analgésica natural.
¿Qué es la papaína?
La papaína es otra enzima digestiva popular y funciona de manera similar a la bromelina para apoyar la salud digestiva de nuestras mascotas.
También se ha demostrado que la papaína es tan eficaz como la aspirina como agente analgésico y antiinflamatorio en una variedad de afecciones médicas.
La papaya y la piña son dos de las fuentes vegetales más ricas en enzimas digestivas. La papaína y la bromelina son los nombres respectivos de las enzimas proteolíticas que se encuentran en estas frutas.
Los beneficios de la papaína para perros:
- Ayuda digestiva.
- Alivio natural del dolor.
Cómo funciona:
El uso principal de las enzimas proteolíticas (como la papaína y la bromelina) es como ayuda digestiva.
Las enzimas digestivas pueden ayudar a evitar este problema llamado "intestino permeable". Pueden ser útiles para una amplia variedad de otras afecciones de salud, especialmente alergias alimentarias (presumiblemente al digerir la comida tan bien que hay menos a qué ser alérgico), dermatitis atópica (alérgica), bolas de pelo, artritis, enfermedad inflamatoria intestinal y autoinmune enfermedades.
Pancrelipasa:
Apoya la función pancreática y es crucial para una digestión normal.
¿Qué es la pancrelipasa?
La pancrelipasa es una combinación de tres enzimas (proteínas): lipasa, proteasa y amilasa. Estas enzimas son normalmente producidas por el páncreas y son cruciales para una digestión normal.
La pancrelipasa se usa para reemplazar estas enzimas cuando el cuerpo no tiene suficiente.
La pancrelipasa se elabora a partir del páncreas de los cerdos.
Los beneficios de la pancrelipasa:
- Combinación de tres enzimas producidas por el páncreas que son cruciales para la digestión normal.
- Mejora la función pancreática.
- Ofrecer apoyo para los trastornos pancreáticos.
- Ayuda en el procesamiento de carbohidratos, grasas y proteínas.
Cómo funciona:
La pancrelipasa mejora la función pancreática (ayuda al páncreas a descomponer los carbohidratos, las grasas y las proteínas).
Se utiliza para tratar trastornos pancreáticos en mascotas, incluida la insuficiencia pancreática exocrina (EPI) en perros y gatos. La EPI causa una incapacidad para digerir los alimentos normalmente y generalmente es el resultado de episodios repetidos de pancreatitis.
maxxidigest + comienza apoyando el páncreas con pancrelipasa que ayuda a descomponer todos los alimentos ingeridos, incluso los alimentos no tan buenos (altos en carbohidratos).
La pancrelipasa proporciona tres enzimas, lipasa para grasas, amilasa para carbohidratos y proteasa para la digestión de proteínas esenciales para la digestión y absorción de numerosos nutrientes, especialmente grasas.
Vitis vinifera:
Antioxidante, antiinflamatorio y antialérgico.
¿Qué es la vitis vinifera?
Como todos los dueños de perros saben, las uvas pueden ser tóxicas para nuestros perros (no hay informes de gatos que se enfermen a causa de las uvas, pero es poco probable que las coman).
Sin embargo, el extracto de semilla de uva (vitis vinifera) y el aceite de la uva no son tóxicos y ofrecen importantes beneficios para la salud tanto de perros como de gatos.
El extracto de semilla de uva se elabora a partir de las semillas trituradas de la uva (un subproducto de la industria vinícola).
Los beneficios de la vitis vinifera para perros:
- Extracción no tóxica para suplementos.
- Antiinflamatorio.
- Antialérgico.
- antioxidante.
Cómo funciona:
Vitis vinifera contiene ingredientes antiinflamatorios, antialérgicos y antioxidantes.
Lo que lo convierte en un buen ingrediente en una fórmula digestiva e inmunológica avanzada como maxxidigest +.
L-cistina:
Apoya la síntesis de proteínas
¿Qué es la cistina?
La cistina no es lo mismo que la cisteína, pero ambos son aminoácidos.
La cistina juega un papel importante en la síntesis de proteínas; ayuda a determinar la forma final de la proteína.
Los beneficios de la cistina para perros:
- Apoya la síntesis de proteínas.
- Aumenta la eliminación de grasa del torrente sanguíneo.
Cómo funciona:
Los estudios en ratas muestran que la cistina aumenta los niveles de una enzima que elimina las grasas del torrente sanguíneo.
L-taurina:
Ayuda a regular los niveles de agua y sodio en sangre y tiene un efecto calmante.
¿Qué es la taurina?
La taurina es un aminoácido que apoya el desarrollo neurológico, ayuda a regular el nivel de agua y sales minerales en la sangre y tiene propiedades antioxidantes.
Se ha demostrado que la taurina es beneficiosa para la función cardíaca, pero tiene muchos otros beneficios, incluido el efecto calmante y estabilizador en el cerebro (por lo que es uno de los ingredientes clave de nuestra ayuda calmante para perros, maxxicalm).
Los beneficios de la taurina para perros:
- Ayuda a regular los niveles de agua y sodio en sangre.
- Beneficioso para la función cardíaca.
- Tiene un efecto calmante natural sobre la función cerebral.
Deficiencia de taurina:
Los perros pueden sufrir deficiencia de taurina, es decir, si el cuerpo no produce suficiente.
"La taurina se encuentra principalmente en la carne de los músculos y está completamente ausente en los cereales. La falta de taurina en la dieta provocó el desarrollo de graves enfermedades oculares y cardíacas".
¿Qué es el cromo?
El cromo (polinicotinato) es un oligoelemento (metal) que ayuda a mantener normales los niveles de azúcar en la sangre al mejorar la forma en que el cuerpo usa la insulina.
La suplementación con cromo puede ayudar a perder grasa corporal, retener y desarrollar masa corporal magra, disminuir los niveles elevados de azúcar en sangre y reducir los niveles de colesterol en sangre.
Cromo:
Ayuda a controlar los niveles de azúcar y colesterol en sangre.
Los beneficios del cromo para perros:
- Ayuda a perder grasa.
- Ayuda a controlar los niveles de azúcar y colesterol en sangre.
- Estudiado en mascotas tanto para perder peso como para regular la glucosa.
Cómo funciona:
El efecto del cromo en perros y gatos se ha estudiado tanto para la pérdida de peso como para la regulación de la glucosa en diabéticos.
El cromo puede ser útil en animales diabéticos que son difíciles de regular con insulina.
Biotina:
Requerido para el correcto funcionamiento de las enzimas en el cuerpo.
¿Qué es la biotina?
La biotina (o vitamina H o B7) es una de las ocho vitaminas que se encuentran en el complejo B.
Los beneficios de la biotina para perros:
- Apoya la función enzimática.
- Ayuda a mantener la piel y el cabello sanos.
Cómo funciona:
Además de ayudar a mantener la piel y el cabello saludables (además de nuestro Pet Factor Omega 3), la biotina es necesaria para el correcto funcionamiento de las enzimas del cuerpo.
Base en polvo:
Contiene prebióticos vitales y ayuda con la digestión y muchas afecciones relacionadas con el tracto gastrointestinal (GI).
¿Qué hay en la base en polvo?
La base en polvo utilizada en maxxidigest + contiene fibra de lino desgrasada, girasol y semillas de sésamo que también proporciona propiedades inmunológicas y de función hormonal.
Esta es una forma concentrada de fibra que proporciona casi el doble del contenido de lignanos que la harina de lino integral.
La base de maxxidigest + no solo llena, tiene sus propios beneficios para la salud de los perros.
Los lignanos tienen propiedades de equilibrio hormonal:
Los lignanos son un grupo de compuestos químicos que se encuentran en las plantas. Los lignanos son ricos en antioxidantes y fibra, y tienen efectos antiestrogénicos, es decir, pueden ayudar a regular los niveles hormonales.
Lignanos ofrece diversos beneficios para la salud de nuestros perros. Al tener un alto contenido de antioxidantes, apoyan el sistema inmunológico. Si bien las propiedades de equilibrio hormonal de los lignanos significan que son beneficiosos tanto para los animales machos como para las hembras que han sido esterilizados o castrados.
Pero eso no es todo, la base de maxxidigest + también contiene prebióticos vitales
Los beneficios de la base en polvo:
- Los prebióticos son vitales para la supervivencia de los probióticos.
- Ayuda con la digestión y muchas afecciones relacionadas con el tracto gastrointestinal.
- Apoya el sistema inmunológico.
- Ofrecer apoyo para la función hormonal adecuada.
¿Cómo funcionan los prebióticos para los perros?:
La fibra ayuda con la digestión y muchas afecciones relacionadas con el tracto gastrointestinal (GI).
Pediococcus acidilactici es el mejor probiótico para mascotas, pero se necesitan prebióticos para alimentar a los probióticos.
"Los probióticos son bacterias" buenas "que ayudan a mantener su sistema digestivo saludable controlando el crecimiento de bacterias dañinas. Los prebióticos son carbohidratos que el cuerpo humano no puede digerir. Son alimento para los probióticos. El beneficio principal de los probióticos y prebióticos parece estar ayudando mantienes un sistema digestivo saludable".
Esta es una cosa más que hace que maxxidigest + sea diferente de las otras fórmulas digestivas que existen.
Al poner los ingredientes medicinales digestivos y reconstituyentes en una base de fibra de semilla desgrasada a base de lino, girasol y sésamo (los prebióticos) estamos mejorando la función inmunológica al alimentar la flora intestinal de los perros. Al hacerlo, las bacterias prosperarán, limpiarán el medio ambiente y permitirán una mejor absorción de los ingredientes medicinales de la fórmula, así como de la comida de los animales.
Que Pediococcus acidilactici sea menos sensible a la exposición al oxígeno y a la temperatura elevada, también significa que maxxidigest + tiene una vida útil más larga que los probióticos convencionales.
Los estudios confirman que el pediococcus acidilactici funciona.
Los estudios han confirmado que Pediococcus acidilactici no solo es útil para aliviar los efectos secundarios de los medicamentos cuando se administra junto con el tratamiento con medicamentos. P. acidilactici también ayuda a perros y gatos a acelerar su recuperación de enfermedades agudas o crónicas.
"La investigación en animales ha demostrado que P. acidilactici es capaz de equilibrar la microflora intestinal y reducir el riesgo de una salud subóptima. Además, los resultados actuales indican que P. acidilactici es capaz de promover una respuesta inflamatoria saludable en los intestinos, así como apoyar una respuesta inmune saludable. P. acidilactici produce varios compuestos antimicrobianos diferentes que disminuyen el número de bacterias patógenas. Compite activamente contra Listeria "(Jarrow) *
* Las bacterias patógenas son bacterias que pueden causar infecciones.
L-glutamina (glutamina)
Repara la barrera mucosa intestinal dañada y ayuda a optimizar la función inmunológica
¿Qué es la glutamina?
Hay dos tipos de glutamina, pero toda la glutamina que se encuentra en los alimentos o suplementos es L-Glutamina.
La glutamina es un aminoácido no esencial (un componente básico de las proteínas) que se encuentra naturalmente en el cuerpo. Tiene muchas funciones de apoyo para el tracto digestivo.
La suplementación puede mejorar la salud digestiva y optimizar la función del sistema inmunológico (PetMD).
La glutamina sirve como fuente de energía primaria para las células de la mucosa que recubren el tracto intestinal. El estrés en las células intestinales puede aumentar la necesidad de glutamina, p. Ej. debido a enfermedades crónicas del intestino.
Los beneficios de la glutamina para perros:
La suplementación con glutamina se recomienda comúnmente para mascotas con trastornos intestinales agudos o crónicos, incluida la enfermedad inflamatoria intestinal, diarrea crónica, síndrome del intestino permeable y síndrome del intestino irritable.
- Repara la barrera de la mucosa intestinal dañada.
- Ayuda a optimizar la función inmunológica.
- Aminoácido no esencial para proteínas.
Cómo actúa la glutamina:
La L-glutamina construye y calma el tejido inflamatorio en el revestimiento intestinal. Repara la barrera de la mucosa intestinal dañada deteniendo la permeabilidad intestinal, la fuga de proteínas grandes al torrente sanguíneo. También puede conducir a una mejor absorción de nutrientes en el tracto intestinal.
La glutamina también puede reducir la toxicidad gastrointestinal de algunos medicamentos de quimioterapia y puede minimizar la inflamación del tracto intestinal causada por la radioterapia (Withrow y MacEwen's Small Animal Clinical Oncology).
Metilsulfonilmetano (MSM)
Combate eficazmente las inflamaciones resultantes de reacciones autoinmunes y puede ser útil como alivio de alergias.
¿Qué es MSM?
El MSM es la fuente de azufre en el cuerpo.
Quizás sea más conocido por su papel en el apoyo a la salud de las articulaciones, pero los HSH ofrecen otros beneficios para la salud.
Los beneficios del MSM para perros:
- Ayuda a mantener el tejido conectivo sano.
- Apoya el alivio de las reacciones alérgicas.
- Aborda la inflamación resultante de reacciones autoinmunes.
Cómo funciona MSM para perros:
El MSM mantiene el tejido conectivo sano y tiene propiedades antiinflamatorias y dolorosas naturales.
Combate eficazmente las inflamaciones resultantes de reacciones autoinmunes (en las que el sistema inmunológico del cuerpo se activa) y también puede ser útil como alivio de las alergias.
N-acetil-D-glucosamina (NAG):
Ayuda a mantener la permeabilidad intestinal normal al proteger el revestimiento del estómago y los intestinos.
¿Qué es la N-acetil-D-glucosamina?
La glucosamina se presenta en diferentes formas.
La glucosamina HCL y el sulfato de glucosamina son los más conocidos, pero se utilizan comúnmente en suplementos para articulaciones de calidad para perros, como maxxiflex +.
La N-acetil-D-glucosamina, o NAG, es una forma más de glucosamina y se encuentra en la capa exterior de los mariscos.
Los beneficios de NAG para perros:
- Protege el revestimiento del estómago y los intestinos.
- Sulfato que se encuentra en los mariscos.
- Comúnmente tomado para la osteoartritis y enfermedades inflamatorias del intestino.
Cómo funciona:
NAG ayuda a proteger el revestimiento del estómago y los intestinos, es decir, ayuda a mantener la permeabilidad intestinal normal.
La N-acetil-D-glucosamina se toma comúnmente para la osteoartritis y la enfermedad inflamatoria intestinal (EII), incluidas la colitis ulcerosa y la enfermedad de Crohn (PetMD).
Fucus Vesiculosus:
Apoya la función y el metabolismo saludables de la tiroides.
¿Qué es el fucus vesiculosus?
Fucus vesiculosus (también conocido como fucus) es un alga (alga marina) que crece en océanos más fríos en todo el mundo.
Las algas están llenas de nutrientes. Contiene yodo, que se usa para prevenir y tratar algunos trastornos de la tiroides. También proporciona hierro, B12 energizante y fibra dietética, junto con folato (ácido fólico) y riboflavina.
Los beneficios del fucus vesiculosus:
- Yodo natural para el apoyo de la tiroides.
- Aporta hierro, B12, ácido fólico y riboflavina.
- Apoya la función y el metabolismo saludables de la tiroides.
Cómo funciona:
"Ese perfil nutricional sugiere que las algas marinas podrían ayudar a elevar los niveles de energía. El magnesio y la fibra de las algas te ayudarán a evitar el estreñimiento. Algunas pruebas médicas sugieren que las algas pardas pueden combatir algunos cánceres e infecciones" (Healthline).
En pocas palabras, el fucus vesiculosus favorece la función y el metabolismo saludables de la tiroides.
Bromelina:
Auxiliar digestivo de proteínas y antihistamínico natural.
¿Qué es la bromelina?
La bromelina es una enzima natural procedente de la piña.
Se utiliza principalmente para aliviar el dolor y la hinchazón, por lo que encontrará bromelina en nuestro suplemento para articulaciones de perro maxxiflex +.
Pero eso no es todo. La bromelina también ayuda con muchos problemas digestivos.
Los beneficios de la bromelina:
- antihistamínico natural.
- Ayuda digestiva para proteínas.
Cómo funciona:
Los fluidos digestivos en el sistema de nuestro perro y gato destruyen la mayoría de las enzimas ingeridas por vía oral antes de que sean absorbidas. Sin embargo, la bromelina es una enzima proteolítica, es decir, tiene la capacidad de descomponer proteínas.
Esto significa que la bromelina puede ayudar al cuerpo a digerir los alimentos y absorber los nutrientes de manera más eficiente, así como a curar de manera efectiva varios problemas en el tracto gastrointestinal.
La bromelina también es un antihistamínico natural, es decir, digiere la molécula de histamina. La histamina causa alergias, por lo que la bromelina puede ayudar a aliviar algunos de los síntomas de alergia más comunes.
Papaína:
Ayuda digestiva y analgésica natural.
¿Qué es la papaína?
La papaína es otra enzima digestiva popular y funciona de manera similar a la bromelina para apoyar la salud digestiva de nuestras mascotas.
También se ha demostrado que la papaína es tan eficaz como la aspirina como agente analgésico y antiinflamatorio en una variedad de afecciones médicas.
La papaya y la piña son dos de las fuentes vegetales más ricas en enzimas digestivas. La papaína y la bromelina son los nombres respectivos de las enzimas proteolíticas que se encuentran en estas frutas.
Los beneficios de la papaína para perros:
- Ayuda digestiva.
- Alivio natural del dolor.
Cómo funciona:
El uso principal de las enzimas proteolíticas (como la papaína y la bromelina) es como ayuda digestiva.
Las enzimas digestivas pueden ayudar a evitar este problema llamado "intestino permeable". Pueden ser útiles para una amplia variedad de otras afecciones de salud, especialmente alergias alimentarias (presumiblemente al digerir la comida tan bien que hay menos a qué ser alérgico), dermatitis atópica (alérgica), bolas de pelo, artritis, enfermedad inflamatoria intestinal y autoinmune enfermedades.
Pancrelipasa:
Apoya la función pancreática y es crucial para una digestión normal.
¿Qué es la pancrelipasa?
La pancrelipasa es una combinación de tres enzimas (proteínas): lipasa, proteasa y amilasa. Estas enzimas son normalmente producidas por el páncreas y son cruciales para una digestión normal.
La pancrelipasa se usa para reemplazar estas enzimas cuando el cuerpo no tiene suficiente.
La pancrelipasa se elabora a partir del páncreas de los cerdos.
Los beneficios de la pancrelipasa:
- Combinación de tres enzimas producidas por el páncreas que son cruciales para la digestión normal.
- Mejora la función pancreática.
- Ofrecer apoyo para los trastornos pancreáticos.
- Ayuda en el procesamiento de carbohidratos, grasas y proteínas.
Cómo funciona:
La pancrelipasa mejora la función pancreática (ayuda al páncreas a descomponer los carbohidratos, las grasas y las proteínas).
Se utiliza para tratar trastornos pancreáticos en mascotas, incluida la insuficiencia pancreática exocrina (EPI) en perros y gatos. La EPI causa una incapacidad para digerir los alimentos normalmente y generalmente es el resultado de episodios repetidos de pancreatitis.
maxxidigest + comienza apoyando el páncreas con pancrelipasa que ayuda a descomponer todos los alimentos ingeridos, incluso los alimentos no tan buenos (altos en carbohidratos).
La pancrelipasa proporciona tres enzimas, lipasa para grasas, amilasa para carbohidratos y proteasa para la digestión de proteínas esenciales para la digestión y absorción de numerosos nutrientes, especialmente grasas.
Vitis vinifera:
Antioxidante, antiinflamatorio y antialérgico.
¿Qué es la vitis vinifera?
Como todos los dueños de perros saben, las uvas pueden ser tóxicas para nuestros perros (no hay informes de gatos que se enfermen a causa de las uvas, pero es poco probable que las coman).
Sin embargo, el extracto de semilla de uva (vitis vinifera) y el aceite de la uva no son tóxicos y ofrecen importantes beneficios para la salud tanto de perros como de gatos.
El extracto de semilla de uva se elabora a partir de las semillas trituradas de la uva (un subproducto de la industria vinícola).
Los beneficios de la vitis vinifera para perros:
- Extracción no tóxica para suplementos.
- Antiinflamatorio.
- Antialérgico.
- antioxidante.
Cómo funciona:
Vitis vinifera contiene ingredientes antiinflamatorios, antialérgicos y antioxidantes.
Lo que lo convierte en un buen ingrediente en una fórmula digestiva e inmunológica avanzada como maxxidigest +.
L-cistina:
Apoya la síntesis de proteínas
¿Qué es la cistina?
La cistina no es lo mismo que la cisteína, pero ambos son aminoácidos.
La cistina juega un papel importante en la síntesis de proteínas; ayuda a determinar la forma final de la proteína.
Los beneficios de la cistina para perros:
- Apoya la síntesis de proteínas.
- Aumenta la eliminación de grasa del torrente sanguíneo.
Cómo funciona:
Los estudios en ratas muestran que la cistina aumenta los niveles de una enzima que elimina las grasas del torrente sanguíneo.
L-taurina:
Ayuda a regular los niveles de agua y sodio en sangre y tiene un efecto calmante.
¿Qué es la taurina?
La taurina es un aminoácido que apoya el desarrollo neurológico, ayuda a regular el nivel de agua y sales minerales en la sangre y tiene propiedades antioxidantes.
Se ha demostrado que la taurina es beneficiosa para la función cardíaca, pero tiene muchos otros beneficios, incluido el efecto calmante y estabilizador en el cerebro (por lo que es uno de los ingredientes clave de nuestra ayuda calmante para perros, maxxicalm).
Los beneficios de la taurina para perros:
- Ayuda a regular los niveles de agua y sodio en sangre.
- Beneficioso para la función cardíaca.
- Tiene un efecto calmante natural sobre la función cerebral.
Deficiencia de taurina:
Los perros pueden sufrir deficiencia de taurina, es decir, si el cuerpo no produce suficiente.
"La taurina se encuentra principalmente en la carne de los músculos y está completamente ausente en los cereales. La falta de taurina en la dieta provocó el desarrollo de graves enfermedades oculares y cardíacas".
¿Qué es el cromo?
El cromo (polinicotinato) es un oligoelemento (metal) que ayuda a mantener normales los niveles de azúcar en la sangre al mejorar la forma en que el cuerpo usa la insulina.
La suplementación con cromo puede ayudar a perder grasa corporal, retener y desarrollar masa corporal magra, disminuir los niveles elevados de azúcar en sangre y reducir los niveles de colesterol en sangre.
Cromo:
Ayuda a controlar los niveles de azúcar y colesterol en sangre.
Los beneficios del cromo para perros:
- Ayuda a perder grasa.
- Ayuda a controlar los niveles de azúcar y colesterol en sangre.
- Estudiado en mascotas tanto para perder peso como para regular la glucosa.
Cómo funciona:
El efecto del cromo en perros y gatos se ha estudiado tanto para la pérdida de peso como para la regulación de la glucosa en diabéticos.
El cromo puede ser útil en animales diabéticos que son difíciles de regular con insulina.
Biotina:
Requerido para el correcto funcionamiento de las enzimas en el cuerpo.
¿Qué es la biotina?
La biotina (o vitamina H o B7) es una de las ocho vitaminas que se encuentran en el complejo B.
Los beneficios de la biotina para perros:
- Apoya la función enzimática.
- Ayuda a mantener la piel y el cabello sanos.
Cómo funciona:
Además de ayudar a mantener la piel y el cabello saludables (además de nuestro Pet Factor Omega 3), la biotina es necesaria para el correcto funcionamiento de las enzimas del cuerpo.
Base en polvo:
Contiene prebióticos vitales y ayuda con la digestión y muchas afecciones relacionadas con el tracto gastrointestinal (GI).
¿Qué hay en la base en polvo?
La base en polvo utilizada en maxxidigest + contiene fibra de lino desgrasada, girasol y semillas de sésamo que también proporciona propiedades inmunológicas y de función hormonal.
Esta es una forma concentrada de fibra que proporciona casi el doble del contenido de lignanos que la harina de lino integral.
La base de maxxidigest + no solo llena, tiene sus propios beneficios para la salud de los perros.
Los lignanos tienen propiedades de equilibrio hormonal:
Los lignanos son un grupo de compuestos químicos que se encuentran en las plantas. Los lignanos son ricos en antioxidantes y fibra, y tienen efectos antiestrogénicos, es decir, pueden ayudar a regular los niveles hormonales.
Lignanos ofrece diversos beneficios para la salud de nuestros perros. Al tener un alto contenido de antioxidantes, apoyan el sistema inmunológico. Si bien las propiedades de equilibrio hormonal de los lignanos significan que son beneficiosos tanto para los animales machos como para las hembras que han sido esterilizados o castrados.
Pero eso no es todo, la base de maxxidigest + también contiene prebióticos vitales
Los beneficios de la base en polvo:
- Los prebióticos son vitales para la supervivencia de los probióticos.
- Ayuda con la digestión y muchas afecciones relacionadas con el tracto gastrointestinal.
- Apoya el sistema inmunológico.
- Ofrecer apoyo para la función hormonal adecuada.
¿Cómo funcionan los prebióticos para los perros?:
La fibra ayuda con la digestión y muchas afecciones relacionadas con el tracto gastrointestinal (GI).
Pediococcus acidilactici es el mejor probiótico para mascotas, pero se necesitan prebióticos para alimentar a los probióticos.
"Los probióticos son bacterias" buenas "que ayudan a mantener su sistema digestivo saludable controlando el crecimiento de bacterias dañinas. Los prebióticos son carbohidratos que el cuerpo humano no puede digerir. Son alimento para los probióticos. El beneficio principal de los probióticos y prebióticos parece estar ayudando mantienes un sistema digestivo saludable".
Esta es una cosa más que hace que maxxidigest + sea diferente de las otras fórmulas digestivas que existen.
Al poner los ingredientes medicinales digestivos y reconstituyentes en una base de fibra de semilla desgrasada a base de lino, girasol y sésamo (los prebióticos) estamos mejorando la función inmunológica al alimentar la flora intestinal de los perros. Al hacerlo, las bacterias prosperarán, limpiarán el medio ambiente y permitirán una mejor absorción de los ingredientes medicinales de la fórmula, así como de la comida de los animales.Ver más
Enlace copiado.




